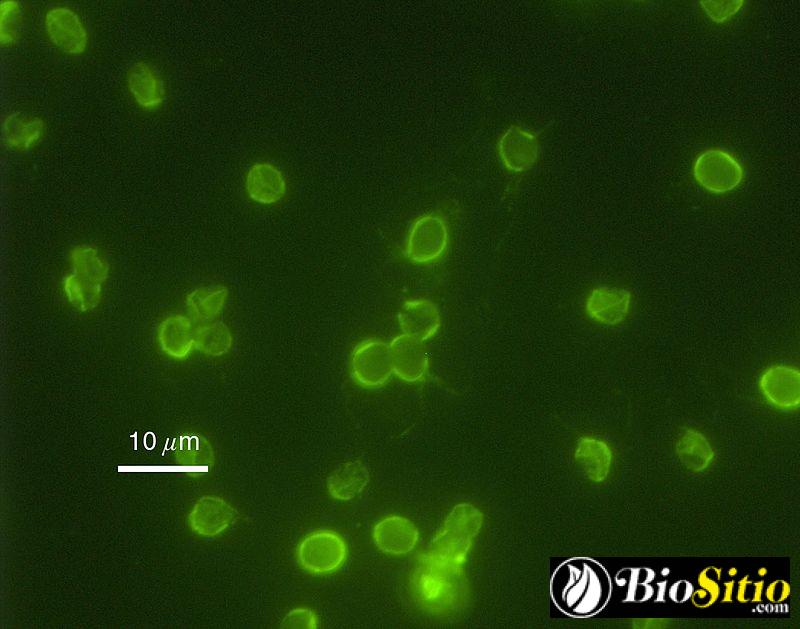

Los flagelados son un grupo de protozoos que se caracterizan por tener uno o varios flagelos que les permiten desplazarse. Estos organismos son muy diversos y se encuentran en diferentes ambientes acuáticos, desde agua dulce hasta mares profundos.
En este artículo exploraremos las características y hábitos de los flagelados, así como su importancia ecológica en los ecosistemas acuáticos. ¡Acompáñanos a descubrir más sobre estos fascinantes microorganismos!
Flagelados

Los flagelados son un grupo de protozoos unicelulares que se caracterizan por tener uno o varios flagelos que utilizan para desplazarse y captar alimentos. Estos organismos son muy diversos y se encuentran en una gran variedad de ambientes, desde el agua dulce hasta el suelo y el tracto intestinal de los animales.
Importancia ecológica
Los flagelados tienen una gran importancia ecológica, ya que son parte fundamental de la cadena alimentaria en muchos ecosistemas acuáticos y terrestres. Algunos flagelados son fitoplancton, es decir, que realizan fotosíntesis y son la base de la alimentación de muchos animales acuáticos, como pequeños crustáceos y peces. Otros flagelados son zooplancton, es decir, que se alimentan de otros organismos y son a su vez alimento de animales más grandes.
Además, los flagelados son importantes en la descomposición de materia orgánica, ya que muchos de ellos son saprótrofos y se alimentan de restos de plantas y animales. De esta forma, contribuyen a la liberación de nutrientes en los ecosistemas y al ciclo del carbono.
Importancia médica
Algunos flagelados son parásitos humanos y animales y pueden causar enfermedades graves. Por ejemplo, el género Trypanosoma incluye especies que causan la enfermedad del sueño en humanos y la enfermedad de Chagas en animales y humanos. Estas enfermedades son endémicas en muchas regiones tropicales y subtropicales del mundo y afectan a millones de personas.
Otro ejemplo es el género Giardia, un parásito que vive en el intestino de muchos animales, incluyendo humanos. La infección por Giardia puede causar diarrea crónica y desnutrición, especialmente en niños y personas con sistemas inmunológicos debilitados.
Importancia en la investigación científica
Los flagelados son organismos modelo en la investigación científica, ya que son unicelulares y tienen una gran diversidad de formas y funciones celulares. Por ejemplo, el género Chlamydomonas es utilizado como modelo para estudiar la fotosíntesis y la movilidad celular, mientras que el género Trypanosoma es utilizado para estudiar la biología molecular de los parásitos y para desarrollar nuevos tratamientos contra las enfermedades que causan.
¿Cómo se clasifican dentro del grupo de los protozoos?
Dentro del grupo de los protozoos, los flagelados se clasifican en la subclase Mastigophora, que se divide en dos órdenes: el orden Zoomastigophora, que incluye a los flagelados libres, y el orden Retortamonadida, que agrupa a los parásitos intestinales. Además, algunos flagelados también se clasifican en otros grupos de protozoos, como los ciliados y los apicomplejos.
Entre los flagelados más conocidos se encuentran los géneros Trypanosoma, que causa la enfermedad de Chagas y la enfermedad del sueño, y Giardia, responsable de infecciones gastrointestinales en humanos y animales.
¿Cuál es la función principal del flagelo en los flagelados?
La función principal del flagelo en los flagelados es la locomoción. El flagelo es una estructura filamentosa que se mueve de forma ondulante y permite el desplazamiento de estos organismos acuáticos. Además de la locomoción, en algunos flagelados el flagelo también puede ser utilizado para capturar alimento o para la reproducción. Es importante destacar que no todos los flagelados tienen flagelos, algunos tienen cilios u otros tipos de estructuras de movilidad.
¿Cómo es el proceso de reproducción en los flagelados y cuáles son sus características?
Los flagelados son un grupo diverso de organismos unicelulares que se caracterizan por tener uno o varios flagelos que les permiten moverse en medios acuosos. En cuanto a su reproducción, existen dos tipos principales: la reproducción asexual y la reproducción sexual.
En la reproducción asexual, el flagelado se divide en dos células hijas idénticas mediante un proceso llamado fisión binaria. Este proceso es común en flagelados como los parásitos intestinales Giardia lamblia y Trichomonas vaginalis.
Por otro lado, en la reproducción sexual, los flagelados pueden fusionarse para formar una célula híbrida que luego se divide en células hijas. Este proceso se llama conjugación y es común en flagelados como Chlamydomonas reinhardtii y Euglena gracilis.
Cabe destacar que los flagelados presentan una gran diversidad morfológica y funcional, y que estas características influyen en su proceso de reproducción. Algunos flagelados pueden también alternar entre reproducción asexual y sexual según las condiciones ambientales.
¿Cómo se alimentan los flagelados y cuál es su papel en la cadena alimentaria?
Los flagelados son organismos unicelulares que utilizan flagelos para moverse y capturar alimentos. Su modo de alimentación varía según la especie.
Algunos flagelados son autótrofos y producen su propio alimento a través de la fotosíntesis, como es el caso de algunos géneros de algas flageladas. Otros son heterótrofos y se alimentan de materia orgánica, como bacterias y otros microorganismos.
En su papel dentro de la cadena alimentaria, los flagelados son importantes consumidores primarios y secundarios, ya que pueden ser una fuente importante de alimento para otros organismos acuáticos, como crustáceos y pequeños peces. Además, algunos flagelados son parásitos y pueden causar enfermedades en otros organismos. En resumen, los flagelados son una parte importante del ecosistema acuático y su presencia y función en la cadena alimentaria son fundamentales para mantener el equilibrio y la biodiversidad del medio ambiente acuático.
¿Cuáles son algunas enfermedades que pueden ser causadas por los flagelados y cómo se transmiten?
Los flagelados son un grupo de organismos unicelulares que pueden causar diversas enfermedades en humanos y animales. Algunas de las enfermedades que pueden ser causadas por los flagelados incluyen:
- 1. Enfermedad del sueño: es causada por el parásito Trypanosoma brucei, que es transmitido por la mosca tse-tse en África.
- 2. Leishmaniasis: es causada por el parásito Leishmania, que es transmitido por la picadura de mosquitos flebotomos en regiones tropicales y subtropicales.
- 3. Enfermedad de Chagas: es causada por el parásito Trypanosoma cruzi, que es transmitido por chinches triatominos en América Latina.
- 4. Tricomoniasis: es una infección vaginal o uretral causada por el protozoo Trichomonas vaginalis, que se transmite principalmente por contacto sexual.
- 5. Giardiasis: es una infección intestinal causada por el protozoo Giardia lamblia, que se transmite a través del agua contaminada con heces humanas o animales.
- 6. Enfermedad de Whipple: es una infección rara causada por la bacteria Tropheryma whipplei, que se transmite por vía oral-fecal.
En resumen, los flagelados pueden causar diversas enfermedades que se transmiten por diferentes vías, como la picadura de insectos, el contacto sexual, la ingesta de agua contaminada y la exposición a heces humanas o animales.
¿Cuál es la importancia ecológica de los flagelados y cómo contribuyen a mantener el equilibrio en los ecosistemas acuáticos?
Los flagelados son organismos unicelulares que se encuentran en una gran variedad de ecosistemas acuáticos. Su importancia ecológica radica en que son una parte esencial de la cadena alimentaria, ya que son consumidos por otros organismos acuáticos y a su vez se alimentan de bacterias y otros microorganismos.
Contribución al equilibrio de los ecosistemas acuáticos: Los flagelados son importantes para mantener un equilibrio en los ecosistemas acuáticos, ya que controlan la población de bacterias y otros microorganismos. Al ser consumidos por otros organismos, los flagelados transfieren energía a lo largo de la cadena alimentaria y ayudan a regular las poblaciones de otros organismos acuáticos.
Importancia en la producción de alimentos: Los flagelados también tienen una gran importancia en la producción de alimentos acuáticos, como los mariscos. Al ser una fuente de alimento para los animales acuáticos de mayor tamaño, los flagelados contribuyen a la producción de alimentos para consumo humano.
Papel en la ecología del fitoplancton: Algunos flagelados forman parte del fitoplancton, el cual es una comunidad de organismos acuáticos que realizan fotosíntesis y producen oxígeno. Estos flagelados también son importantes para el ciclo del carbono en los ecosistemas acuáticos.
En resumen, los flagelados son organismos unicelulares que cumplen una función importante en la cadena alimentaria y en la regulación de las poblaciones de otros organismos acuáticos. Además, son esenciales para la producción de alimentos y en la ecología del fitoplancton, contribuyendo así al equilibrio de los ecosistemas acuáticos.
Conclusión
En conclusión, los flagelados son un grupo de protozoos que se caracterizan por tener flagelos que les permiten desplazarse. Estos organismos unicelulares pueden ser parásitos o de vida libre, y se encuentran en diversos ambientes acuáticos y terrestres. Los flagelos, además de permitirles la locomoción, también son importantes para otras funciones como la captura de alimento y la reproducción.
Entre los flagelados más conocidos se encuentran los Trypanosomas, responsables de enfermedades como la enfermedad del sueño y la enfermedad de Chagas. También están los Giardia, que causan diarrea, y los Trichomonas, que pueden infectar el tracto genital humano.
Es importante destacar que los flagelados son organismos muy diversos y que aún se están descubriendo nuevas especies. Además, su estudio es fundamental para entender la biodiversidad y la ecología de los ecosistemas acuáticos y terrestres.
En resumen:
- Los flagelados son protozoos con flagelos que les permiten desplazarse.
- Pueden ser parásitos o de vida libre.
- Los flagelos también cumplen otras funciones importantes.
- Entre los flagelados más conocidos están los Trypanosomas, Giardia y Trichomonas.
- El estudio de los flagelados es fundamental para entender la biodiversidad y ecología de los ecosistemas.
¡Comparte este artículo!
Si te ha gustado este artículo sobre los flagelados, ¡no dudes en compartirlo en tus redes sociales! Ayuda a difundir el conocimiento sobre la biología y los seres vivos. Además, si tienes alguna pregunta o comentario, déjanos saber en la sección de comentarios. ¡Nos encantaría saber tu opinión! Y si deseas ponerte en contacto con el administrador de este blog, puedes hacerlo a través del formulario de contacto. ¡Gracias por visitarnos!